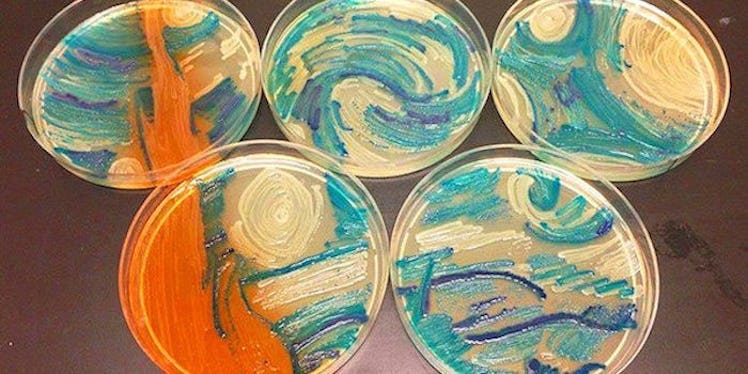

Scientists Used Different Bacteria To Make Amazing Art Masterpieces (Photos)
Believe it or not, bacteria can be used to create fine art.
No, seriously, some skilled microbiologists made headlines by using microbes and germs to create vivid works of art. And they're not making just any kind of art. They're recreating famous paintings by well-known artists like Vincent van Gogh!
In addition to recreating classic paintings with bacteria, the microbiologists also created their own original pieces.
The "paintings" were created to compete in the American Society for Microbiology's first-ever Agar Art challenge.
Check out the bacteria art below for a closer look!
Using different types of bacteria and microbes, microbiologists created their own art pieces using agar, a jelly-like substance from algae.
Each piece, crafted by microbiologists from all around the world, was submitted to the Agar Art challenge, an event hosted by the American Society for Microbiology.
This piece, called "Flowering Sunshine," was made from Shigella and Salmonella bacteria.
Maria Eugenia Inda came in third place with this piece, titled "Harvest Season," made with Saccharomyces cerevisiae.
At first sight, you'd probably think these colors are paints, but they're not. The piece is actually made out of Candida albicans, Candida glabrata and Candida parapsilosis.
Perhaps one of the most intricate pieces on display was the recreation of van Gogh's "The Starry Night," pictured below.
First place winner of the Agar Art challenge was "Neurons" by Mehmet Berkmen and artist Maria Penil, and it was made using Nesterenkonia, Deinococcus and Sphingomonas.
The People's Choice went to "Cell to Cell," another piece made by the previous duo featuring the same bacteria.
My personal favorite was "The Streptomyces Sky" made with Streptomyces coelicolor.
If there's anything we can learn from this, it's not all bacteria are gross. In fact, they help create some pretty awesome art!
Citations: Microbiologists Create 'Starry Night' And Other Art With Bacteria For First Microbe Art Competition (Bored Panda), Announcing the 2015 ASM Agar Art Winners #agarart (MicrobeWorld)